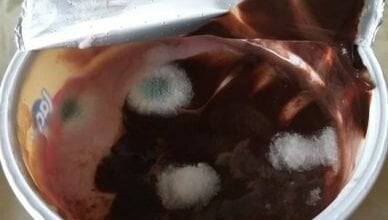
В Николаеве в крупном супермаркете продают десерт с плесенью | Корабелов.ИНФО

День: 12.09.2019
-
Происшествия
%22%20transform%3D%22translate(.8%20.8)%20scale(1.52344)%22%20fill-opacity%3D%22.5%22%3E%3Cellipse%20fill%3D%22%23c2bdc3%22%20rx%3D%221%22%20ry%3D%221%22%20transform%3D%22matrix(-79.96753%20-34.43946%2017.2821%20-40.12858%2046%20132)%22%2F%3E%3Cellipse%20fill%3D%22%23445c00%22%20rx%3D%221%22%20ry%3D%221%22%20transform%3D%22matrix(-22.32757%20-31.94574%2066.51382%20-46.48794%20223.9%2027)%22%2F%3E%3Cellipse%20fill%3D%22%23b7bfdd%22%20cx%3D%22230%22%20cy%3D%22135%22%20rx%3D%2253%22%20ry%3D%2237%22%2F%3E%3Cellipse%20fill%3D%22%231e283b%22%20rx%3D%221%22%20ry%3D%221%22%20transform%3D%22matrix(-70.11801%2050.94372%20-16.08728%20-22.14225%2019.3%2015.1)%22%2F%3E%3C%2Fg%3E%3C%2Fsvg%3E)
В Харькове педофил снимал на видео изнасилование школьницы
У мужчины, задержанного по факту изнасилования 12-летней школьницы в Харькове, изъяли мобильный телефон с видео, подтверждающим его причастность к преступлению. Об этом…
-
Общество
%27%20fill-opacity%3D%27.5%27%3E%3Cellipse%20fill%3D%22%23e8e4e5%22%20fill-opacity%3D%22.5%22%20rx%3D%221%22%20ry%3D%221%22%20transform%3D%22rotate(46.4%20-13%2075.2)%20scale(65.21675%20377.78116)%22%2F%3E%3Cellipse%20fill-opacity%3D%22.5%22%20rx%3D%221%22%20ry%3D%221%22%20transform%3D%22rotate(-55.6%20255.3%20-97)%20scale(134.47133%2092.79345)%22%2F%3E%3Cellipse%20fill%3D%22%23a3aba8%22%20fill-opacity%3D%22.5%22%20rx%3D%221%22%20ry%3D%221%22%20transform%3D%22rotate(-166.7%20201.7%2046.7)%20scale(52.01516%20128.02323)%22%2F%3E%3Cellipse%20fill%3D%22%23a5647a%22%20fill-opacity%3D%22.5%22%20rx%3D%221%22%20ry%3D%221%22%20transform%3D%22matrix(31.98197%2014.91344%20-79.95776%20171.46996%2019.6%20206)%22%2F%3E%3C%2Fg%3E%3C%2Fsvg%3E)
В Николаеве в крупном супермаркете продают десерт с плесенью
Жительница Николаева Инна купила в крупном супермаркете десерт "Дольче", под крышкой которого оказалась плесень. Об этом она написала в Facebook-группе "Николаев — лучший…
-
Общество
%27%20fill-opacity%3D%27.5%27%3E%3Cellipse%20fill%3D%22silver%22%20fill-opacity%3D%22.5%22%20rx%3D%221%22%20ry%3D%221%22%20transform%3D%22matrix(57.49175%2041.96956%20-69.149%2094.72336%2032%20190.4)%22%2F%3E%3Cellipse%20fill%3D%22%23464646%22%20fill-opacity%3D%22.5%22%20rx%3D%221%22%20ry%3D%221%22%20transform%3D%22matrix(8.2552%20-62.7045%20127.08619%2016.73121%20195.2%2017.6)%22%2F%3E%3Cellipse%20fill%3D%22%23bebebe%22%20fill-opacity%3D%22.5%22%20rx%3D%221%22%20ry%3D%221%22%20transform%3D%22rotate(-128.9%20222%2028.2)%20scale(98.46867%2060.18728)%22%2F%3E%3Cellipse%20fill%3D%22%23454545%22%20fill-opacity%3D%22.5%22%20rx%3D%221%22%20ry%3D%221%22%20transform%3D%22matrix(7.72628%2051.91601%20-37.4107%205.56756%20189.6%20177.4)%22%2F%3E%3C%2Fg%3E%3C%2Fsvg%3E)
"Другого места для парковки я не нашла", - скандальная депутат Веселовская объяснила свое нарушение ПДД
Как сообщалось ранее, 12 сентября депутат Николаевского городского совета Лариса Веселовская из Корабельного района неправильно припарковала свой автомобиль "Pegeout" и из-за этого…
-
Происшествия
%27%20fill-opacity%3D%27.5%27%3E%3Cellipse%20fill%3D%22%23a8a8a9%22%20fill-opacity%3D%22.5%22%20rx%3D%221%22%20ry%3D%221%22%20transform%3D%22matrix(47.04991%2031.25989%20-40.37548%2060.76998%20166.7%20163.4)%22%2F%3E%3Cellipse%20fill%3D%22%232b2b2c%22%20fill-opacity%3D%22.5%22%20rx%3D%221%22%20ry%3D%221%22%20transform%3D%22matrix(11.9102%20136.13424%20-48.59372%204.2514%20287.7%20160.6)%22%2F%3E%3Cpath%20fill%3D%22%23a2a2a3%22%20fill-opacity%3D%22.5%22%20d%3D%22M68.7%20234.6l-67.5%2012L-36.7%2032l67.5-12z%22%2F%3E%3Cellipse%20fill%3D%22%23767676%22%20fill-opacity%3D%22.5%22%20rx%3D%221%22%20ry%3D%221%22%20transform%3D%22matrix(38.51395%20-38.9194%2027.18749%2026.90426%20231%20144.8)%22%2F%3E%3C%2Fg%3E%3C%2Fsvg%3E)
Кроме $90 тысяч, были еще и 300 тыс.грн.: главного дорожника Николаевской области подозревают в получении двух взяток
Детективы Национального антикоррупционного бюро Украины по согласованию с Специализированной антикоррупционной прокуратурой сообщили руководителю Службы автомобильных дорог в Николаевской области Андрею Максименко о…
-
Общество
%27%20fill-opacity%3D%27.5%27%3E%3Cellipse%20fill%3D%22%23282828%22%20fill-opacity%3D%22.5%22%20rx%3D%221%22%20ry%3D%221%22%20transform%3D%22matrix(-.79353%2056.94463%20-158.1933%20-2.20445%2077.7%20.8)%22%2F%3E%3Cellipse%20fill%3D%22silver%22%20fill-opacity%3D%22.5%22%20rx%3D%221%22%20ry%3D%221%22%20transform%3D%22matrix(-1.27125%20-33.92658%2070.58166%20-2.64473%2091.6%20113)%22%2F%3E%3Cpath%20fill%3D%22silver%22%20fill-opacity%3D%22.5%22%20d%3D%22M403.8%2080.2l-8%20152-60.8-3.1L343%2077z%22%2F%3E%3Cellipse%20fill%3D%22%23464646%22%20fill-opacity%3D%22.5%22%20rx%3D%221%22%20ry%3D%221%22%20transform%3D%22matrix(64.71093%20-55.26835%2035.884%2042.01476%20232.1%20172.8)%22%2F%3E%3C%2Fg%3E%3C%2Fsvg%3E)
"Він бачив її очі, сповнені ненависті": депутатка з Корабельного району грубо порушила ПДР та майже не наїхала на пішохода (Відео)
У четвер, 12 вересня, депутатка Лариса Веселовська (мешканка мікрорайону Кульбакіно, від якого й була обрана до Миколаївської міськради), скоївши правопорушення, намагалася втекти…
-
Политика
%27%20fill-opacity%3D%27.5%27%3E%3Cellipse%20fill%3D%22%23e18d70%22%20fill-opacity%3D%22.5%22%20rx%3D%221%22%20ry%3D%221%22%20transform%3D%22matrix(381.46807%20-73.45917%2010.15148%2052.71588%20147.4%2022.9)%22%2F%3E%3Cellipse%20fill%3D%22%23192a32%22%20fill-opacity%3D%22.5%22%20rx%3D%221%22%20ry%3D%221%22%20transform%3D%22rotate(83.4%20-18.3%20226.5)%20scale(113.11792%20189.32315)%22%2F%3E%3Cellipse%20fill%3D%22%23b490bc%22%20fill-opacity%3D%22.5%22%20rx%3D%221%22%20ry%3D%221%22%20transform%3D%22matrix(27.65248%20-74.35527%2054.81327%2020.38487%20238.2%205.5)%22%2F%3E%3Cpath%20fill%3D%22%23b27d31%22%20fill-opacity%3D%22.5%22%20d%3D%22M180.5-13l-204.1%201.6%2029%20176.7z%22%2F%3E%3C%2Fg%3E%3C%2Fsvg%3E)
Уроженец Винничины с милицейским прошлым и стремительной карьерой: что известно о новом главе Николаевской СБУ
Виталий Герсак, которого Президент Владимир Зеленский назначил начальником УСБУ в Николаевской области, до этого занимал должность заместителя начальника департамента внутренней безопасности Службы…
-
Общество
%22%20transform%3D%22translate(.8%20.8)%20scale(1.52344)%22%20fill-opacity%3D%22.5%22%3E%3Cellipse%20fill%3D%22%236c6c6c%22%20cx%3D%2287%22%20cy%3D%227%22%20rx%3D%2294%22%20ry%3D%2219%22%2F%3E%3Cellipse%20fill%3D%22%23cdcdcd%22%20cx%3D%2271%22%20cy%3D%2269%22%20rx%3D%22254%22%20ry%3D%2223%22%2F%3E%3Cellipse%20fill%3D%22%23d0d0d0%22%20rx%3D%221%22%20ry%3D%221%22%20transform%3D%22matrix(11.74921%2078.62016%20-35.01564%205.23283%20240.3%2066)%22%2F%3E%3Cellipse%20fill%3D%22%23929292%22%20rx%3D%221%22%20ry%3D%221%22%20transform%3D%22matrix(-28.93162%20166.06783%20-17.87253%20-3.11367%20162.8%2077.7)%22%2F%3E%3C%2Fg%3E%3C%2Fsvg%3E)
Мэр Сенкевич вручил ключи от 3-комнатной квартиры педиатру, проработавшей только 1,5 месяца
В четверг, 12 сентября, молодой врач-педиатр Алла Николаенко, которая этим летом окончила интернатуру и только с августа приступила к работе в семейной…
-
Происшествия
%27%20fill-opacity%3D%27.5%27%3E%3Cellipse%20fill-opacity%3D%22.5%22%20rx%3D%221%22%20ry%3D%221%22%20transform%3D%22matrix(1.2847%20-53.20635%20374.82815%209.0505%20108.2%20181.4)%22%2F%3E%3Cellipse%20fill%3D%22silver%22%20fill-opacity%3D%22.5%22%20rx%3D%221%22%20ry%3D%221%22%20transform%3D%22rotate(90.5%2086%20121)%20scale(73.02797%20280.53065)%22%2F%3E%3Cellipse%20fill%3D%22%23bebebe%22%20fill-opacity%3D%22.5%22%20rx%3D%221%22%20ry%3D%221%22%20transform%3D%22rotate(167.7%20118.1%2030.4)%20scale(87.08409%2057.98014)%22%2F%3E%3Cellipse%20fill%3D%22%23050505%22%20fill-opacity%3D%22.5%22%20rx%3D%221%22%20ry%3D%221%22%20transform%3D%22matrix(-145.72083%20.72442%20-.25512%20-51.31766%20101.4%20196.5)%22%2F%3E%3C%2Fg%3E%3C%2Fsvg%3E)
В России мужчину убило током на мойке самообслуживания (видео)
В Дагестане мужчину убило током на мойке самообслуживания. На видео видно, что 53-летний клиент заехал в комплекс в селении Кочубей. Загнал автомобиль,…
-
Общество
%27%20fill-opacity%3D%27.5%27%3E%3Cellipse%20fill%3D%22%230d0e07%22%20fill-opacity%3D%22.5%22%20rx%3D%221%22%20ry%3D%221%22%20transform%3D%22matrix(-215.16472%203.38008%20-1.1686%20-74.38877%20272.8%20203.7)%22%2F%3E%3Cellipse%20fill%3D%22%23c4c3d5%22%20fill-opacity%3D%22.5%22%20rx%3D%221%22%20ry%3D%221%22%20transform%3D%22rotate(-88.8%20149.1%20-136.2)%20scale(72.91946%20177.00741)%22%2F%3E%3Cellipse%20fill%3D%22%23e6e7dd%22%20fill-opacity%3D%22.5%22%20rx%3D%221%22%20ry%3D%221%22%20transform%3D%22rotate(174%20-.4%2052)%20scale(43.80482%2071.43972)%22%2F%3E%3Cellipse%20fill%3D%22%23665bc1%22%20fill-opacity%3D%22.5%22%20rx%3D%221%22%20ry%3D%221%22%20transform%3D%22matrix(81.04821%20-33.0251%2019.45576%2047.74717%20225.9%2093)%22%2F%3E%3C%2Fg%3E%3C%2Fsvg%3E)
У депутата горсовета от Корабельного района изъяли авто из-за долгов в 5 млн гривен – он это отрицает
Заводской отдел государственной исполнительной службы города Николаева из-за задолженности по кредитам изъял автомобиль у депутата Николаевского городского совета Владислава Ентина, избранного от…